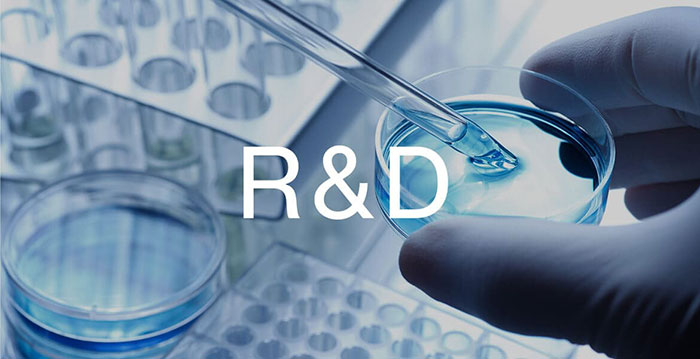
セルバンクの研究開発

企業情報
ABOUT CELLBANK
- HOME
- 企業情報
再生医療の新しい地平を
切り拓くために。
当社は、真の社会的付加価値を誠実かつ公平さを保ちながら創造するという理念の下、
再生医療の新しい地平を切り拓くために生まれました。
医療の常識や慣習にとらわれない自由な発想で、迅速かつ効率的に社会に技術やサービス提供することを通じて、
再生医療分野におけるリーディングカンパニーとなることをミッションとして捉えています。
セルバンクの主要事業
若い時の細胞を凍結して保管しておくことができる細胞保管事業を含め、
再生医療の普及・啓蒙が私たちのミッションです。